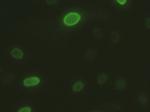
DFF45 Antibody in Immunocytochemistry (ICC/IF)

Search
OriGene
DFF45 Monoclonal Antibody (OTI1B10), TrueMAB™
{{$productOrderCtrl.translations['antibody.pdp.commerceCard.promotion.promotions']}}
{{$productOrderCtrl.translations['antibody.pdp.commerceCard.promotion.viewpromo']}}
{{$productOrderCtrl.translations['antibody.pdp.commerceCard.promotion.promocode']}}: {{promo.promoCode}} {{promo.promoTitle}} {{promo.promoDescription}}. {{$productOrderCtrl.translations['antibody.pdp.commerceCard.promotion.learnmore']}}
产品信息
CF500061
宿主/亚型
分类
类型
克隆号
抗原
偶联物
形式
浓度
规格
保存条件
运输条件
产品详细信息
For reconstitution, we recommend adding 100 µL distilled water to a final antibody concentration of about 1 mg/mL. To use this carrier-free antibody for conjugation experiments, we strongly recommend performing another round of desalting. (Zeba Spin Desalting Columns, 7KMWCO, 0.5 mL, Product # 89882)
靶标信息
ICAD is the inhibitor of caspase-3-activated DNase which is a substrate that controls nuclear apoptosis. ICAD has two isoforms: a functional isoform of 45kDa, ICAD-L/DNA fragmentation factor (DFF) 45; and a 35kDa isoform, ICAD-S/DFF35. Although both ICAD-L and ICAD-S can bind and inhibit CAD, only ICAD-L was reported to be functional. ICAD is cleaved to be inactivated and allow caspase-activated DNase (CAD) to execute nuclear internucleosomal apoptotic DNA fragmentation. In non-apoptotic cells, CAD is complexed with its inhibitor, ICAD. The activation of the CAD/ICAD complex occurs through the caspase 3-mediated cleavage of ICAD at residues 117 and 224, which results in three ICAD fragments that are then released from CAD. In addition to its DNase inhibitory activity, ICAD acts as a CAD specific folding chaperone. There are recent reports that ICAD is a potential target for restoring a normal apoptotic signal transduction pathway in colon and brain cancer cells. Two alternatively spliced transcript variants encoding distinct isoforms have been found for the ICAD gene.
仅用于科研。不用于诊断过程。未经明确授权不得转售。